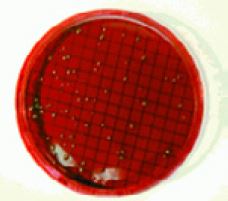

Питательные среды в микротубах по 2 мл
Брошюры
Все файлы в формате PDF. Для просмотра файлов используйте Adobe Reader.
Питательные среды в микротубах (ампулах) по 2 мл для использования «на один фильтр» 47 мм при микробиологическом анализе методом мембранной фильтрации.
Желчный бульон с бриллиантовым зеленым 2%
Содержит два ингибитора (медицинская желчь, бриллиантовый зеленый), которые действуют на грам-положительные и некоторые грам-отрицательные микроорганизмы. Ферментация определяется по выделению газа при инкубировании.
Цетримидный бульон
Питательна вреда для определения Pseudomonas aeruginosa (синегнойной палочки) за счет синтеза пиоцианина (сине-зеленый, растворимый в воде, не флюоресцентный феназиновый пигмент), индуцируемого содержащимися в питательной среде хлориду магния и сульфату калия. Питательная среда также содержит цетримид (N-цетил-N,N,N-триметиламмоний бромид), который ингибирует развитие фоновых микроорганизмов, т.к. является четвертичным аммонийным катионным детергентом, вызывающим вымывание азота и фосфора из клеток бактерий, за исключением Pseudomonas aeruginosa.
Коли-тест с MUG
Используется для предварительной идентификации кишечной палочки и определения ее наличия в пробах воды. Коли-тест не является количественным, определяет присутствие / отсутствие E. coli в пробе.
Бульон для Escherichia Coli (EC)
Бульон ЕС содержит казеиновый пептон и лактозу, являющиеся источником питательных веществ для колиформных бактерий и Escherichia сoli. При этом лактозоположительные бактерии утилизируют лактозу с образованием газа. Рост грамположительные бактерий ингибируются смесью желчных солей.
Бульон для Escherichia Coli (EC) c MUG
Наличие флюоресценции при использовании длинноволнового источника УФ-излучения достоверно подтверждает присутствие Escherichia Coli,. MUG позволяет определить анаэрогенные штаммы, не определяемые классическим методом. Питательная среда содержит лактозу в качестве источника энергии, казеиновый пептон в качестве источника питательных веществ. Смесь желчных солей является ингибитором для грам-положительных бактерий, в частности, бацилл и фекальных стрептококков. Флюорогенный субстрат, 4-метилумбеллиферил-b-D-глюкуронид, гидролизируется β-глюкуронидазой, характерной для большинства штаммов Escherichia Coli, и некоторых штаммов сальмонелл, шигелл и иерсиний, что приводит к появлению флуоресцирующего конечного продукта, 4-метилумбеллиферона.
Бульон для энтерококков
Бульон для энтерококков является модифицированной средой Сланетца-Бартли с ТТХ. Контроль на энтерококки осуществляется методом мембранной фильтрации, прост в исполнении, не требует дополнительного подтверждения и позволяет провести количественный анализ за 48 часов.
HPC (Heterotrophic Plate Count) бульон и HPC бульон с ТТХ используется для определения общего числа колиформ при инкубировании при 35 ºC. При инкубировании на индикаторной среде HPC колонии окрашиваются в красный цвет в результате преципитации формазана, который образуется в результате восстановления бактериями 2,3,5-трифенилтетразолия хлорида.
Бульон KF для стрептококков
Бульон КФ для стрептококков используется для селективного выделения фекальных стрептококков в сточных водах. Мальтоза и лактоза содержатся в качестве источников углерода, азид натрия является селективным агентом, бромкрезоловый фиолетовый является индикаторным красителем.
Лаурилсульфатный / лаурилтриптозный бульон
Данная питательная среда была разработана Американской ассоциацией здравоохранения (APHA) для определения колиформных микроорганизмов. Данная питательная среда используется на первом этапе стандартного микробиологического анализа воды.
Маннитол-солевой бульон
Маннитол-солевой бульон является богатой питательной средой за счет содержания пептонов и мясного экстракта. Рост большинство бактерий (не стрептококков) ингибируется высокими концентрациями хлорида натрия. Микроорганизмы, которые способны ферментировать маннитол, например, Staphylococcus aureus, вызывают изменение рН питательной среды. За счет присутствия кислотно-основного индикатора фенолового красного колонии приобретают желтую окраску.
Мембранный лаурилсульфатный бульон
Данная питательная среда была разработана для определения колиформных микроорганизмов. Является стандартной питательной средой для определения Escherchia Coli в Великобритании. Данная среда заменяет собой обогащенный мембранный бульон с содержанием 0,4% Teepol 610.
М-эндо колиформный бульон
М-эндо – это питательная среда красного цвета, которую необходимо хранить в затемненных условиях во избежание обесцвечивания. Рост грам-положительных бактерий на данной питательной среде ингибируется дезоксихолатом и лаурилсульфатом. Добавление этанола к питательной среде усиливает ее ингибирующие свойства. Лактозаферментирующие микроорганизмы образуют альдегиды, которые при взаимодействии с реагентом Шиффа (основный фуксин и сульфит натрия) способствуют формированию красных ореолов вокруг колоний. Колиформные колонии приобретают красную окраску с характерным металлическим блеском.
Бульон M-FC
Для развития фекальных колиформ при повышенной температуре (44,5 °C).
Бульон M-FC с розоловой кислотой
Питательная среда по назначению аналогична бульону M-FC. Розоловая кислота ингибирует рост большинства микроорганизмов, не оказывая подобного действия на фекальные колиформы.
M-Green бульон для дрожжей и плесени
Бромкрезоловый зеленый в составе данной питательной среды диффундирует в грибной мицелий, где изменяет окраску за счет щелочной реакции внутриклеточного содержимого. Продукты обмена, выделяемые в питательную среду, изменяют ее рН, что подавляет рост бактерий. Остаточный бромкрезоловый зеленый в питательной среде под влиянием кислотного рН изменяет окраску на желтый цвет.
Селективный M-Green бульон
Селективный M-Green бульон разработан для определения дрожжей и плесени методом мембранной фильтрации при контроле сладких напитков. Данная питательная среди имеет низкий рН, за счет чего подавляется рост бактерий. Также в состав среды входит хлорамфеникол, который дополнительно подавляет рост бактерий, позволяя сформироваться дрожжевым колониям и произвести их подсчет.
Бульон МI и агар МI
МI-бульон позволяет определить наличие колиформных бактерий по активности фермента β-галактозидазы, которая расцепляет субстрат MUGal с образованием 4-метилумбеллиферона, который флуоресцирует в УФ-спектре. Неколиформные микроорганизмы не продуцируют данный фермент и, следовательно, не флуоресцируют. Escherichia coli определяется благодаря субстрату IBDG. β-глюкуронидаза, синтезируемая Escherichia coli, расщепляет субстрат с образованием продукта цвета индиго, окрашивающего колонии. Поскольку E. coli также относится к БГКП, она образует β-галактозидазу и флуоресцирует в УФ-спектре. В состав питательной среды, кроме того, входит антибиотик цефзулодин, который подавляет рост грам-положительных и некоторых неколиформных грамотрицательных бактерий, которые могли бы дать ложноположительные результаты.
Бульон MRS
Питательная среда способствует богатому росту всех видов лактобацилл, в том числе медленно растущих штаммов.
Среда M-TGE для подсчета ОМЧ
Питательная среда способствуют формированию колоний всеми видами микроорганизмов, что позволяет использовать ее для подсчета общего числа микроорганизмов и предварительной морфологической оценки колоний.
Питательная среда с экстрактом апельсина (Orange Serum Broth)
Используется для определения микроорганизмов, вызывающих порчу фруктовых концентратов и соков. Такими микроорганизмами считаются молочнокислые, уксуснокислые бактерии например, Lactobacillus, Leuconostoc) и дрожжи. Экстракт апельсина при рН от 5,4 до 5,6 способствует наилучшему росту нежелательных микроорганизмов как в смешанных культурах
Картофельно-декстрозный бульон и агар
Считается, что эта питательная среда дает наиболее достоверные результаты при определении подсчета дрожжей и плесени в молочных продуктах. Картофельный экстракт в составе среды способствует росту мицелиальных грибов. Для подавления роста бактерий в среду может быть добавлен стерильный раствор винной кислоты до рН 3,5±0,2.
PRY-бульон
Устойчивый к консервантам (бульон для определения дрожжей Preservative Resistant Yeas brotht) является селективной средой с низким рН для определения микроорганизмов, вызывающих порчу напитков и воды.
Бульон для псевдомонад
Питательна вреда для определения Pseudomonas aeruginosa (синегнойной палочки) за счет синтеза пиоцианина (сине-зеленый, растворимый в воде, не флюоресцентный феназиновый пигмент), индуцируемого содержащимися в питательной среде хлориду магния и сульфату калия. Антимикробный компонент иргазан селективно ингибирует грам-положительные и грам-отрицательные микроорганизмы, не относящиеся к псевдомонадам. Глицерин в составе питательной среды является источником углерода, а также способствует синтезу пиоцианина.
Дектрозный бульон Сабуро
Пептон в составе питательной среды является источником азота для развития грибов. Декстроза выступает в качестве источника энергии для роста микроорганизмов. Низкий рН способствует развитию грибков, особенно дерматофитов, но в то же время подавляет развитие сопутствующих бактерий, особенно в клинических образцах.
Стандартный агар (Standard Methods Agar)
Питательная среда способствуют формированию колоний всеми видами микроорганизмов, что позволяет использовать ее для подсчета общего числа микроорганизмов и предварительной морфологической оценки колоний.
Среда для определения ОМЧ с ТТХ
Все бактерии развиваются в данной питательной среде и изменяют окраску индикатора на красный цвет в результате преципитации формазана, образующегося при восстановлении бактериями 2,3,5-трифенилтетразол (ТТХ).
Триптон-соевый бульон нормальной концентрации
Среда общего назначения, используемая при качественном анализе стандартных и требовательных микроорганизмов. Соответствует требованиям DIN 10167 к определению E.coli серотипа О157: H7 в пищевых продуктах и FDA-BAM к выделению энтерогеморрагических штаммов E. coli (EHEC). Cостав питательной среды соответствует USP.
Триптиказно-соевый бульон двойной концентрации
Поддерживает рост широкого спектра микроорганизмов, включая аэробные, факультативнj-анаэробные и анаэробные бактерии и грибы.
Бульон Валлерштайна (WL) и дифференциальный бульон Валлерштайна (WLD)
Бульон WL предназначен для культивации и подсчета дрожжей, а дифференциальный бульон WLD используется для подсчета бактерий. Использование среды при рН 5,5 и инкубирование при 25°C дает достоверные результаты для подсчета пивных дрожжей. Корректировка рН до значения 6,5 и инкубирование при 30°C способствует селективному росту пекарских и винных дрожжей.
Информация для заказа
|
Каталожный номер |
Наименование, описание |
|
Питательные среды в минитубах (2 мл) |
|
|
10496146 |
Cetrimide Broth, 50/pk |
|
10496120 |
Enterococcus Broth, 50/pk |
|
10496164 |
Heterotrophic Plate Count (HPC) Broth, 2 mL , 50/pk |
|
10496151 |
HPC Broth, 50/pk |
|
10496125 |
KF-Streptococcus Broth, 50/pk |
|
10496121 |
Mannitol Salt Broth, 50/pk |
|
10496103 |
M-Endo Coliform Broth, 50/pk |
|
10496124 |
M-FC media, 50/pk |
|
10496114 |
M-FC Broth with rosolic acid, 50/pk |
|
10496116 |
M-Green Select Broth, 50/pk |
|
10496101 |
M-Green Yeast and Mold Broth, 50/pk |
|
10496192 |
MI-Broth Media, 50/pk |
|
10496112 |
MRS Broth, 50/pk |
|
10496102 |
M-TGE Broth, 50/pk |
|
10496104 |
Orange Serum Broth, 50/pk |
|
10496106 |
PRY Both 2 mL 50/pk |
|
10496119 |
Pseudomonas Broth, 50/pk |
|
10496113 |
Total Count Broth with TTC, 50/pk |
|
10496108 |
Wallerstein Broth, 50/pk |
|
10496109 |
Wallerstein Differential Broth, 50/pk |
|
Питательная среда в пробирках, 9 мл |
|
|
10496710 |
Brilliant Green Bile Bottled Broth, with Durham tubes, 20/pk |
|
10496714 |
EC Bottled Broth, with Durham tubes, 20/pk |
|
10496709 |
EC with MUG, Bottled Broth, 20/pk |
|
10496722 |
Lauryl Sulfate/ Lauryl Tryplose Broth |
|
Питательная среда во флаконах, 100 мл |
|
|
10496851 |
MI Media, Bottled Broth, 50 mL, 1/pk |
|
10496847 |
MI Media, Bottled Agar, 50 mL, 1/pk |
|
10496705 |
M-Green Yeast and Mold Bottled Agar, 100 mL, 1/pk |
|
10496707 |
Trypticase Soy Broth (TSB) Single strength, Bottled Broth, 100 mL, 1/pk |
|
10496708 |
Trypticase Soy Broth (TSB) Double strength, Bottled Broth, 100 mL, 1/pk |
|
Набор для экспресс-теста |
|
|
10496744 |
ColiCheck with MUG, PIA Test Kit with Sample Bottles, 30/pk |
Узнайте больше
Ваше сообщение успешно отправлено. Спасибо.